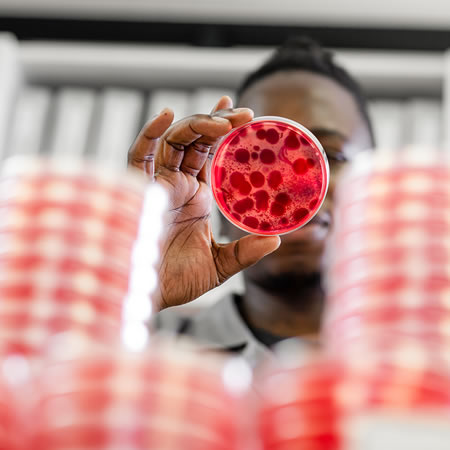

Who Are We
AssureCloud, operating under Aspirata Auditing Testing and Certification (Pty) Ltd, is Southern Africa's most comprehensive and trusted certification body.
ABOUT US
With more than 20 years of experience across food safety, environmental, veterinary, and occupational hygiene services, AssureCloud is internationally accredited by both JASANZ (Australia/New Zealand) and SANAS (South Africa).
Assurecloud has a large footprint across South Africa and representation in Zambia. This allows us to carry out testing close to source with minimal impact on transport and storage of samples, to deliver quick and accurate results. All our laboratories are ISO/IEC 17025:2017 accredited.

OUR LABORATORIES
We have custom-built, state-of-the-art chemical, diagnostic and microbiological laboratories enabling us to provide a broad range of testing and examination services. Our broad geographic footprint allows us to carry out testing close to source, with minimal transport and storage impacts on samples, and to deliver quick and accurate results.
MICROBIOLOGICAL LABORATORY
We offer a broad range of services for microbiological testing of swabs, water samples for all the major pathogenic, indicator and spoilage microorganisms.
Micro Testing:

CHEMISTRY LABORATORY
Assurecloud’s chemical laboratories are equipped with state-of-the-art chromatographic and mass spectrometric instruments in support of our endeavours to consistently provide the best analytical and testing services. Our services include the determination of the physical and chemical characteristics of test samples and the identification and determination of target components in a variety of matrices, including food, feed, water, environmental and products. The target components are determined by client needs.
|
Water and Waste Chemistry Testing
Nutritional Testing
CO₂ Analysis and Testing
|
Food Chemistry Testing
Histamine and Heavy Metal Testing
Raw Milk Testing
|

INDUSTRIES WE SERVE
Our services extend across the farm-to-fork value chain, including:

COMMITMENT TO INTEGRITY AND IMPACT
For more information, go here: https://assurecloud.co.za
